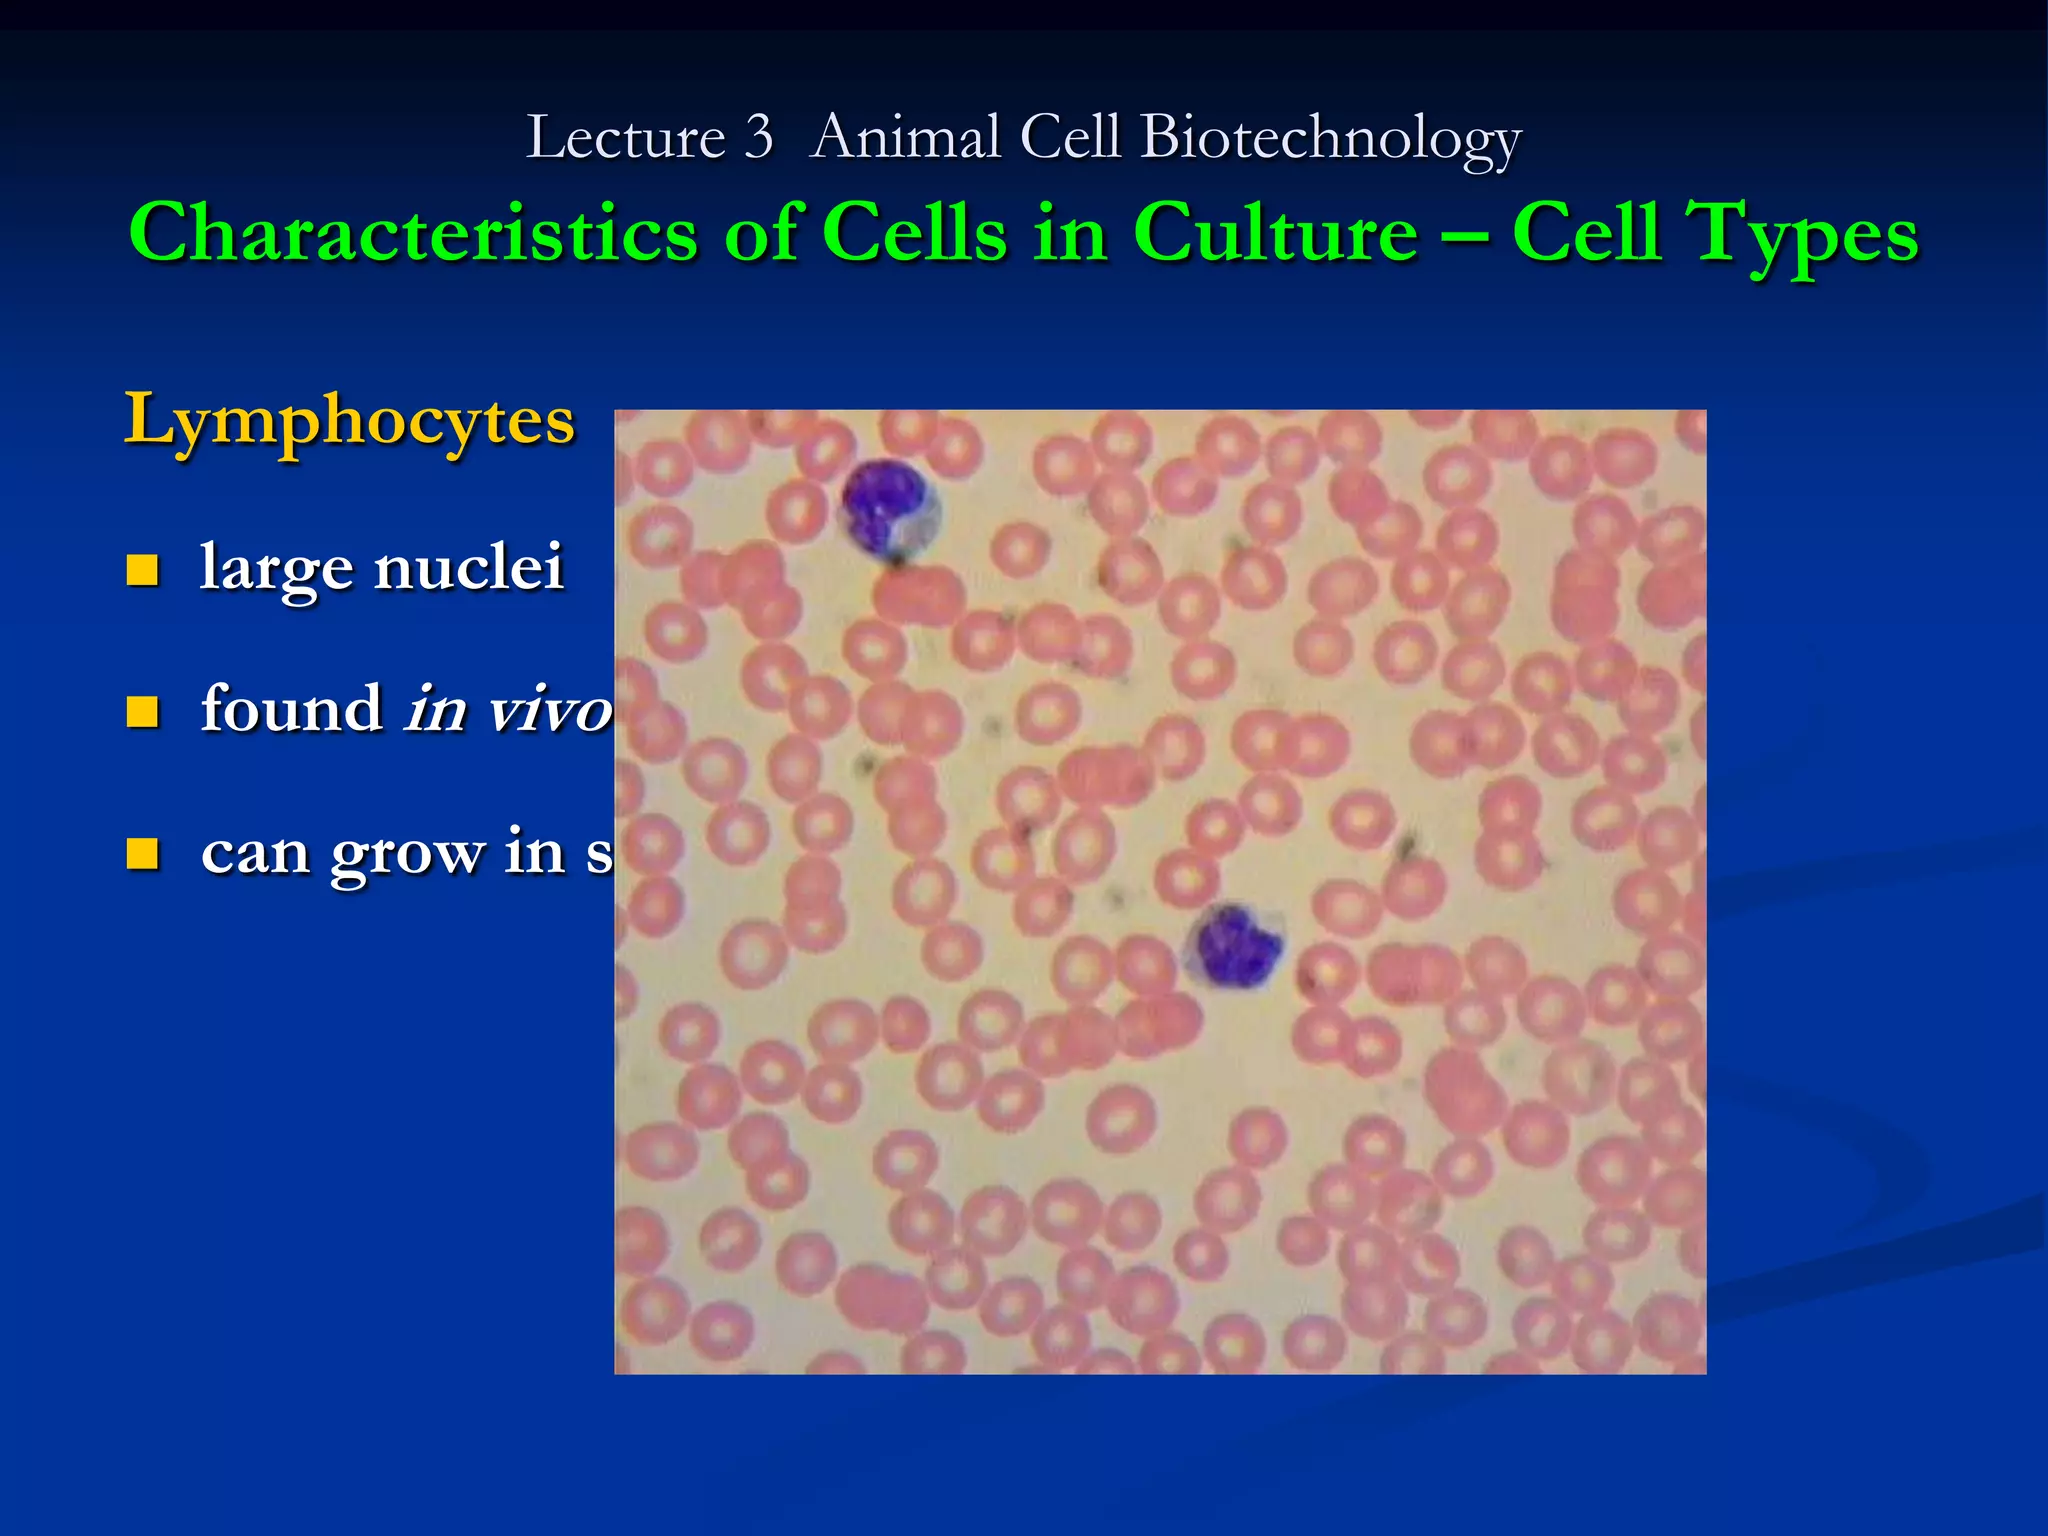
Lecture 3 Animal Cell Biotechnology
Characteristics of Cells in Culture – Cell Types

Lymphocytes
   large nuclei
   found in vivo in blood (liquid suspension)
   can grow in suspension in liquid medium in lab

This lecture discusses characteristics of animal cell cultures. It begins by describing primary cultures established directly from tissue using mechanical and enzymatic methods. Specific cell types are then discussed, including fibroblasts, epithelial cells, muscle cells, neurons, and lymphocytes. The concepts of normal vs. transformed cells, anchorage dependence, passaging, contamination, cell differentiation, and stem cells are also covered. Common cell lines available from culture collections are listed at the end.